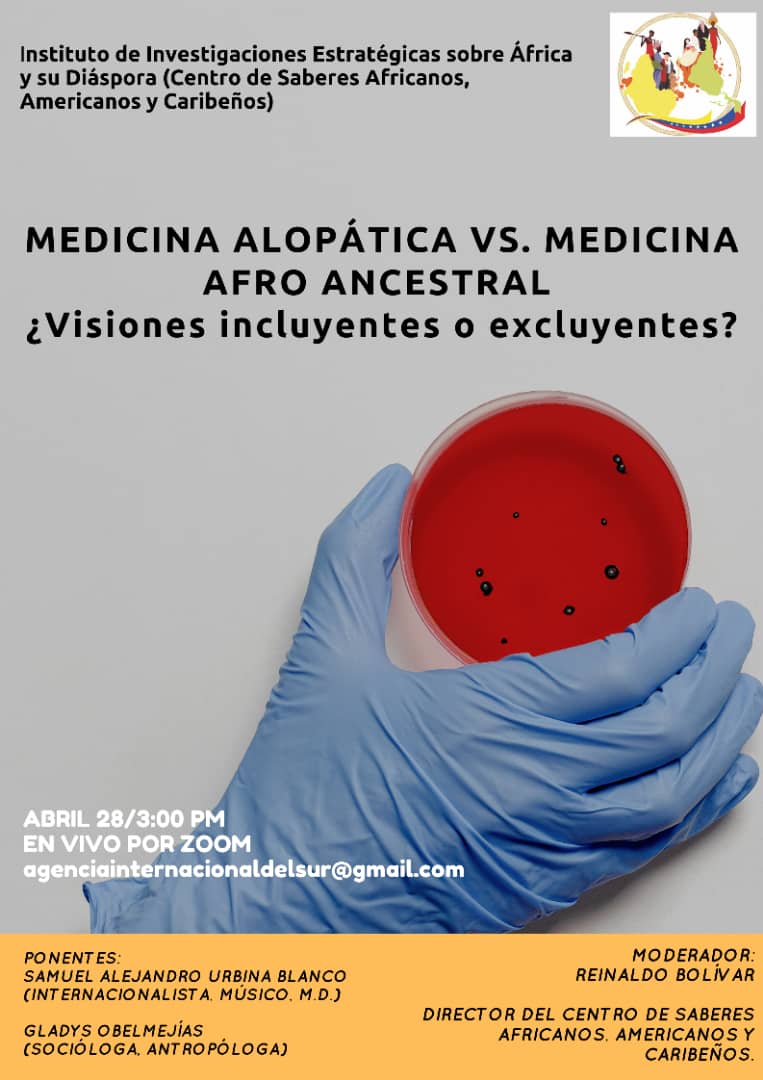
Interculturalidad

Venezuela y Túnez, siglos de historia común

Nuevos africanistas y caribeñistas egresan del Centro de Saberes Africanos

Trump y Nuestra América #ElMundoEnVenezuela 04-02-2025

Aprendizaje Generacional Madre e hija crean vínculos a través del Diplomado de Egipto en Venezuela

Autoridades de Burkina Faso y Mali visitaron el Centro de Saberes Africanos, Americanos y Caribeños

Salutación a Venezuela, del Centro de Saberes Africanos, por el inicio del período presidencial 2025-2031 de Nicolás Maduro Moros

Saludo de Navidad 2024 y Año Nuevo 2025 del Centro de Saberes Africanos

Jean jacques Dessalines ante las luchas emancipadoras haitianas y caribeñas

Sionismo se posiciona como quinta columna en Latinoamérica

Con contundente declaración en apoyo a Haití, a Palestina y un llamado a la unidad de la izquierda concluye VII Congreso de África y el Sur Global (Ver inglés y francés)

Memorias del VI Congreso. Conflictos actuales y nuevas tendencias políticas en el Sur Globalizante.

Programacion VII Congreso Internacional de Saberes Africanos y del Sur Global

Cierra el Registro de Inscripciones para el VII Congreso Internacional de Saberes Africanos y del Sur Global

Ponencias seleccionadas al VII Congreso Internacional de Saberes Africanos y del Sur Global

Embajador Reinaldo Bolívar presentó Cartas Credenciales al Presidente de Túnez

Conferencia sobre «Homenaje a los Ancestros»

Directiva del Centro Massarat sostuvo encuentro con embajador Reinaldo Bolívar

Egipto hace hincapié en todo su apoyo a la región de África en el Sahel en la lucha contra el terrorismo

Túnez participará en la 19a Sesión Ordinaria de la Conferencia Ministerial y en la 23a Reunión Ordinaria de la COMESA

Cumbre de los BRICS mostró la ineficiencia de Occidente para aislar a Rusia, según Lavrov

Palestina rechaza campañas instigadoras israelíes contra la ONU

Embajador Reinaldo Bolívar intervino en acto “Mártires de la Resistencia” en Túnez

Egipto condena aprobación del Knesset israelí de proyecto de ley que prohibía operaciones de la UNRWA

Presidente Maduro: «Un mundo nuevo ha nacido con los BRICS»

Embajada de Venezuela en Egipto participa en Congreso Mundial sobre Población

Fondo de Desarrollo China-África interesado en asociación con Etiopía

Venezuela y Libia trabajan en agenda conjunta de cooperación

Venezuela acredita nueva Embajadora en Guinea Ecuatorial

Comercio Rusia-África creció entre el 25% en enero-julio de 2024, dice Putin

Los países en desarrollo deberían promover la cooperación Sur-Sur en medio de desafíos globales

China condena sanciones contra Zimbabwe

Presidente Maduro se reúne con Primer Ministro de Etiopía, Abiy Ahmed Ali

Presidente Maduro sostuvo fructífero encuentro con su homólogo palestino

Sudáfrica exhorta a usar fuerza del Brics para construir mundo mejor

Venezuela en los BRICS es un avance muy significativo en la nueva geopolítica

El presidente El-Sisi llega a Rusia para asistir a la XVI Cumbre de los BRICS

Líderes de Rusia y Sudáfrica conversan en Cumbre Brics

Voces femeninas bolivarianas desde África- Día mundial contra la lucha del cáncer de mama

Kais Saed preside el Día de la Evacuación en la ciudad tunecina de Bizerte

news Primer ministro haitiano insta al presidente keniano a reforzar misión de seguridad

El presidente El-Sisi, Bin Salman, insta a un alto el fuego en Gaza y Líbano

La construcción de refinerías de petróleo en Congo podría ser el siguiente paso, para los acuerdos entre Rusia y el Congo

Ministros de Defensa africanos recorrieron base aérea de Etiopía

Wangari Maathai, la primera africana ganadora del Premio Nobel de la Paz. La Madre de los árboles

Embajadores de Venezuela y China en Túnez sostienen fraterno encuentro

Egipto apoya la cooperación inclusiva entre los países de la Cuenca del Nilo

Rusia trabaja con África para elaborar memorandos sobre el uso del subsuelo, dice Ministerio de Recursos Naturales

Israel continúa bombardeos contra zonas del sur y norte de Líbano

Etiopía pide soluciones concretas a problemas de seguridad en África

Dbeibah felicita a Kais Saied por su reelección como presidente de Túnez

El Congo espera que Rusia participe en la construcción de una refinería de petróleo, afirma un ministro

Egipto impulsa campaña diplomática para detener agresiones israelíes

IGAD felicitó a Uganda por Día de Independencia

La República Popular de China muestra preocupación por creciente inestabilidad en Medio Oriente

Tebboune felicita al Jefe del Estado tunecino por su reelección como Presidente de la República

Egipto sigue siendo un pilar de estabilidad en la región según el Primer Ministro Madbouly

Rusia entrega ayuda a desplazados libaneses en Siria

Parlamento de Kenya debate destitución del vicepresidente

Aseguran que África está lista para liderar en sector tecnológico

¿Para qué, después de 30 años, seguir en la docencia universitaria?

Abierto el Registro de Inscripciones para el VII Congreso Internacional de Saberes Africanos y del Sur Global

Túnez hace revisión de las herramientas de gobernanza internacional, en la Cumbre del Futuro en Nueva York

Egipto rechaza cualquier violación de la soberanía libanesa: Abdelatty a los ministros árabes

La Universidad de Addis Abeba elabora un atlas lingüístico exhaustivo para Etiopía

Burkina Faso afirma su interés en integrar el grupo BRICS

Guterres urge a evitar en Líbano un conflicto como el de Gaza

México celebra día de independencia con desfile cívico militar

Kais Saied espera realizar un segundo mandato, para erradicar la corrupción y restaurar la economía en Túnez

El jefe de inteligencia y el ministro de Relaciones Exteriores de Egipto discuten los acontecimientos regionales con el presidente eritreo Afwerki en Asmara

AES se enfrenta a los desafíos de los adversarios, incluida Ucrania, según Assimi Goita

Sochi acogerá la reunión inaugural de ministros de Asuntos Exteriores de Rusia y África los días 9 y 10 de noviembre

Etiopía celebra Día de la Identidad como un derecho humano

Reinaldo Bolívar presentó Copias de Estilo como Embajador ante la República de Túnez

Neo descolonización: el caso de Nueva Caledonia y su repercusión en algunas colonias francesas.

Ministro de Relaciones Exteriores de Túnez participa en la 162ª sesión de la Liga Árabe en El Cairo

Ministro dominicano afirma su país tiene deuda millonaria con Caracas

45˚ aniversario de la siembra del primer Presidente de Angola

Dirigente árabe reclama tregua en Gaza y pide evitar guerra regional

Visita de la líder política, Nangula Geingos, al Centro de Saberes Africanos

Rusia está interesada en la cooperación económica con África, dice el Ministerio de Relaciones Exteriores de Rusia

El volumen comercial China-África aumentó un 2,7% en enero-agosto

Túnez aspira a una mayor flexibilidad en términos comerciales con China

Soldados kenianos activos en Haití y con un solo herido

Argelinos convocados a comicios presidenciales el sábado próximo

Egipto solicita formalmente la intervención del Consejo de Seguridad de la ONU en relación con la Gran Presa del Renacimiento Etíope

China aboga por reforzar relaciones con países africanos en Focac

Ministro de Asuntos Exteriores de Túnez realiza llamadas a varios de sus homólogos

Gasoducto transahariano abastecerá al mercado internacional con gas de 3 países africanos

Presidente de Egipto saluda a RPDC por aniversario de su fundación

Presidente de Sudáfrica aprueba una ley sobre seguridad hídrica

Apoyo irrestricto a saharauis y Palestina reitera presidente argelino

Presidente Nicolás Maduro anuncia nuevo Gabinete Ejecutivo

El presidente tunecino, Kais Saied, anuncia una reorganización del gobierno

El Jefe del Gobierno de Túnez recibe al Embajador de la República Popular China

Día de la Comunidad de Desarrollo de África Austral(SADC), y sus relaciones con Rusia

Algunos países violan la soberanía de Malí, dice el jefe de la Fuerza Aérea maliense

Condicionan paz en el Sahara a aplicar resoluciones de la ONU

Los nexos entre India-África, son necesarios para cooperación Sur-Sur

Presidentes africanos felicitan al Presidente Maduro por su reelección

Presidentes asiáticos felicitan reelección del Presidente Maduro

El Banco Africano de Desarrollo financia el empleo en Túnez

Somalia y Egipto firman un acuerdo histórico de defensa, en contra el terrorismo internacional

El comandante de las Fuerzas Armadas de Sudán rechaza el alto el fuego hasta que las RSF se retiren de las ciudades ocupadas

Palestina criticó fracaso global para detener colonización israelí

Etiopía y China lanzaron construcción de zona económica especial

9 de agosto: Día Nacional de la Mujer Sudafricana, referencia de la lucha permanente del Sur-Global

Expertos sobre seguridad y paz en RDC reunidos en Angola

Ministros de Relaciones Exteriores de Egipto, Irán y China debaten esfuerzos para reducir tensiones en Oriente Medio

Níger rompe relaciones diplomáticas con Ucrania por su agresión contra Mali

Diplomáticos de Venezuela y Kenia revisan agenda de cooperación bilateral

Cancilleres de Rusia y Jordania abordan situación en Medio Oriente

Belarús envio felicitaciones al presidente Maduro, por el triunfo en las elecciones presidenciales

El Emir de Catar felicita al presidente de Venezuela, Nicolás Maduro, tras ganar su tercer mandato

Artículo de opinión: CON CABEZA FRÍA

Namibia felicita a Nicolás Maduro por su reelección presidencial

Escalada en Medio Oriente socava objetivos de paz, dice Guterres

Palestina decreta duelo nacional tras asesinato de jefe de Hamas

Rusia llama a respetar la voluntad del pueblo venezolano en comicios

Presidente saharaui desea éxitos a homólogo venezolano

AMLO dice que reconocerá el triunfo de Maduro si el CNE ‘confirma la tendencia’

Declaración de las delegaciones africanas de la Misión de Observación ante las elecciones presidenciales del 28 de julio de 2024 en Venezuela

Presidente Nicolás Maduro recibe felicitaciones de presidentes del sur global

Túnez envía 1.609 toneladas de ayuda humanitaria a Gaza

Canciller de Cuba recuerda natalicio de Simón Bolívar

Presidente egipcio en el aniversario de la revolución de julio

Cooperación Rusia-África: ¿Qué esperar de la sesión del Foro de debate Valdai en Tanzania?

China enfatiza su apoyo a la causa del pueblo palestino

El apagón cibernètico. La renuncia de Biden #ElMundoEnVenezuela 24-07-2024

Félix Da Costa, director de orquesta angoleño, visita el Instituto de Investigaciones Estratégicas sobre África y su Diáspora «Centro de Saberes Africanos, Americanos y Caribeños»

Foro Económico Túnez-Brasil: La cooperación bilateral se acelera para afrontar los desafíos comunes

Canciller sudafricano encabeza delegación a Consejo Ejecutivo de UA

Egipto planea invertir 1.200 millones de dólares para perforar 110 pozos exploratorios durante el año fiscal 2024/2025

Mali abrirá un taller de reparación y montaje de blindados en una fábrica construida en la época de la URSS

Sudáfrica y Zimbabwe ratifican al unísono apoyo a saharauis

El atentado a Trump, repercusiones internacionales #ElMundoEnVenezuela 17-07-2024

FILVEN 2024. Presentación del Libro Conversas llaneras

Túnez: comienza la carrera por los patrocinios en las elecciones presidenciales

Mozambique, Zimbabue y Botswana se unen para un proyecto ferroviario regional

África y China por más cooperación entre gobiernos locales

Concurso de Poesía Afrolatinoamericana y Afrocaribeña «Wanawake»

Concluyó visita de presidente de Timor Leste a Angola

Segunda reflexión sobre acuerdo de paz en Etiopía sesiona en UA

Primer ministro indio finaliza visita a Rusia

Elecciones en Francia y la Confederación del Sahel #ElMundoEnVenezuela 10-07-2024

Los malienses salen a las calles para celebrar la Asociacion de Estados del Sahel

Egipto planea llegar a ser un centro mundial de generación de hidrógeno verde para 2030

Argelia demuestra resultados de operaciones contra terroristas

Presidente egipcio remodela el Gobierno con 20 nuevos ministros

Túnez: El Presidente de la República promulga el decreto de convocatoria de electores, domingo 6 de octubre de 2024

Mauritania: Ould Ghazouani reelegido

Egipto recibió más de siete millones de turistas en primer semestre

Iraq acogerá una reunión reconciliadora entre Siria y Turkiye

Delegación de Etiopía busca estrechar cooperación militar con Uganda

68º aniversario del ejército nacional: Kais Saied reafirma la plena soberanía de Túnez

Presidente de Angola por estrechar cooperación con Costa de Marfil

Comisión Electoral de Sudáfrica ratifica limpieza de elecciones

Destacan debates sobre paz y seguridad en reunión de ente africano

Protestas en Kenia, debido al proyecto de ley de finanzas

Túnez impulsará el comercio con Türkiye

Canciller de Nigeria inicia visita oficial a China

El gobierno de Malí califica de estratégica su cooperación con Rusia

Fuerzas rusas entregan asistencia médica en Siria

Toma de posesión del Presidente reelecto, Cyril Ramaphosa, en Sudáfrica

Acuerdo de subvención beneficiará a sector agrícola de Etiopía

Túnez ocupa el noveno lugar en PIB según paridad de poder adquisitivo en África

Secretario ejecutivo de IGAD dialogó con canciller de Japón

Angola crea condiciones para foro parlamentario de África Austral

Venezuela y Brasil revisan cooperación bilateral en el marco de los BRICS+

Caribe y África buscan oportunidades para el comercio e inversiones

VII Congreso Internacional de Saberes Africanos y del Sur Global en noviembre de 2024, invitación a participar

Cancilleres Yván Gil y Wang Yi ratifican en Beijing amistad y cooperación entre Venezuela y China

Los conflictos hacen más peligrosas las rutas de los migrantes en el Sahel, según la ONU

Bombas de rebeldes en RDC ocasionan muerte de un niño

Presidente de Burkina Faso recibe al canciller de Rusia

Sesiona comité técnico sobre defensa y seguridad de Unión Africana

Etiopía y Türkiye revisan mecanismo de consultas políticas

Partidos de Cuba y Ruanda firman acuerdo de cooperación

Inversión climática para pequeños Estados Insulares en cita caribeña

Petrolera argelina Sonatrach y la SNPC congoleña se asocian para desarrollar los recursos de hidrocarburos

Relaciones China-Guinea Ecuatorial alcanzan mayor nivel

25 de Mayo: Un Homenaje a la Lucha y la Unidad Africana

Canciller Yván Gil: Raisi logró insertar a Irán en los pueblos de América Latina

Argelia despliega recursos para hacer frente al estrés hídrico

Lula: decisión histórica reconocimiento de Estado palestino

Vietnam: el general To Lam elegido como Presidente

Tunez: el presidente Kaïs Saïed vuela a Teherán, para presentar sus condolencias a los iraníes

Dimite primer ministro de Chad tras comicios presidenciales

Siria y Argelia ratifican sólidas relaciones

Rinden homenaje en Teherán a presidente Raisi y mártires de Irán

Irán La revolución continúa #ElMundoEnVenezuela 22-05-2024

Venezuela y Cuba rechazan medidas de EE.UU. contra Nicaragua

Abbas condena agresión israelí y denuncia complicidad de EEUU

Preocupación en Haití por niños deportados solos desde Dominicana

Liga Árabe condena crímenes en Gaza y exige al mundo detener a Israel

Sudáfrica: todo listo para las elecciones generales

Sudáfrica: todo listo para las elecciones generales

El Estado Palestino #ElMundoEnVenezuela 15-05-2024

Canciller sirio se reúne con sus homólogos egipcio y saudita

Mali: se extiende el periodo de transición por tres años

Presidente de Túnez está dispuesto a cooperar con Libia, por la seguridad de ambos países

Rusia juega su papel triunfante en África

Presidente Mahmoud Abbas agradece reconocimiento de Bahamas a Estado palestino

Irán condena ataque israelí contra Rafah

Egipto listo para cualquier escenario tras ataque israelí a Rafah

Mes de la afrodescendencia. Invitado: Modesto Ruiz #ElMundoEnVenezuela 08-05-2024

Egipto condena asalto israelí a cruce de Rafah y alerta consecuencias

Estamos en guerra hasta la libertad, afirma presidente saharaui

Suben a 90 los muertos y 132 desaparecidos por lluvias en Brasil

Suben a 90 los muertos y 132 desaparecidos por lluvias en Brasil

Empresas internacionales de alojamiento de sitios web no darán más servicio a páginas de Venezuela

Siria e Irán valoran acciones para superar sanciones de Occidente

Celebran en Venezuela Día del Trabajador con gran marcha

Celebran en Sudáfrica Día de los Trabajadores

Siria reinaugura proyecto eléctrico con motivo del Primero de Mayo

Benefician a sectores públicos en Nigeria con aumentos salariales

Cuba sigue firme y unida con la Revolución, afirma líder obrero

Venezuela Nuevos egresados en los diplomados y nuevas autoridades en el Centro de Saberes Africanos Americanos y Caribeños

Presidente egipcio rechaza desplazamiento de palestinos de Gaza

Liga Árabe saluda informe sobre agencia de ONU tras ataques israelíes

Oleoducto Níger-Benin: las primeras gotas de petróleo llegan a Sémè Kraké

Pandillas persisten en asedio al Palacio Nacional de Haití

Destacan decisión de Jamaica de reconocer al Estado palestino

ALBA-TCP celebra en Venezuela la XXIII Cumbre de Jefes de Estado

La situación Irán Israel #ElMundoEnVenezuela 24-04-2024

Níger: Manifestantes salen a las calles para protestar contra las fuerzas extranjeras

Zambia solicita ayuda internacional para contrarrestar efectos de la sequía

Arabia Saudita y Pakistán exigen investigación por crímenes en Gaza

Ratifican en Siria apego a principios en aniversario de independencia

Venezuela anunció en reunión Celac retirada de diplomáticos de Ecuador

Autoridades de Venezuela envían mensaje a Presidente de Angola

Palestina presente en las oraciones en Siria por Eid Al-Fiter

Sudáfrica desmiente reportes sobre malas relaciones con la UE

¿Por qué se ha profundizado la disputa entre Somalia y Etiopía?

¿Por qué se ha profundizado la disputa entre Somalia y Etiopía?

Presidentes egipcio y palestino debaten sobre alto el fuego en Gaza

Presidentes egipcio y palestino debaten sobre alto el fuego en Gaza

Autoridades de Ecuador deberán explicar asalto a embajada de México

Diplomado en Estudios del Caribe Insular X cohorte

El mundo condena asalto de Noboa contra la embajada mexicana en Ecuador

Fallece la escritora Maryse Condé, activista contra la esclavitud y el racismo que ganó el “Nobel alternativo”

Senegal: El presidente Diomaye Faye nombra a Ousmane Sonko primer ministro

Consejo de Paz y Seguridad de UA con nuevos miembros

Zimbabue declara desastre por sequía

Líderes de la Resistencia en la región refrendan apoyo a Gaza

Elecciones Presidenciales en Senegal #ElMundoEnVenezuela 03-04-2024

Ciclón Gamane deja 11 muertos a su paso por Madagascar

Ciclón Gamane deja 11 muertos a su paso por Madagascar

Asesora de ONU contra genocidio urge a cumplir cese al fuego en Gaza

Presidente de Mauritania reafirmó apoyo a proceso de paz en RDC

La Autoridad Intergubernamental para el Desarrollo (IGAD) y Sudán del Sur buscan mejorar colaboración

Níger por reforzar la cooperación en materia de seguridad con Rusia

Evalúan proyecto de Corredores de Desarrollo de Addis Abeba, Etiopía

Ejército chadiano elimina una base de operaciones de Boko Haram

El banco más grande de Etiopía dice que ha recuperado la mayor parte del efectivo perdido durante una falla en el sistema

Dominicana y Angola fortalecen relaciones de cooperación

Siria insta a levantar injusto bloqueo impuesto a Cuba

Canciller de Venezuela celebra independencia de Namibia

Presidente de Nigeria suspende los viajes al extranjero financiados con fondos públicos por ministros y funcionarios del gobierno

Lula presentará plan con políticas de igualdad racial en Brasil

Níger: más de 25.000 millones de francos CFA en activos ilícitos recuperados

Jefe de Duma rusa recibe al viceprimer ministro cubano en Moscú

ALBA-TCP denuncia mano de EEUU detrás de planes desestabilizadores

Caribe y África exploran nuevos canales de cooperación

Etiopía acogerá eventos de la industria de la aviación en mayo

La interrupción de Internet afecta a África Occidental y Central, según muestran los datos de Netblocks y Cloudflare

Crisis en Haití: pandillas atacan sede del Ministerio del Interior del país

Destacan en Cuba significado de la Revolución de 1979 en Granada

Kenia suspende el despliegue de la policía en Haití tras el caos que se apodera de la nación caribeña

Aumenta la tensión en Mauritania tras la visita de una delegación europea

ACNUR intenta movilizar hoy más de dos mil millones de dólares para los refugiados en la República Democrática del Congo

Interculturalídad Venezuela Irán #ElMundoEnVenezuela 13-03-2024

Taller «Ser Mujer: el Reencuentro con la Fuente Divina»

Situación en Haití #ElMundoEnVenezuela 06-03-2024

El 27F y la guerra contra el Neoliberalismo ElMundoEnVenezuela 28-02-2024

Embajador de Zimbabwe visita al Centro de Saberes Africanos, Americanos y Caribeños

La Cumbre de la Unión Africana ElMundoEnVenezuela 21-02-2024

Venezuela Inicia segunda cohorte del Diploma de Altos Estudios sobre Egipto

Venezuela: Consejo Nacional de Universidades aprueba Maestría en Estudios y Saberes de África

Rinden homenaje al Bolero, Patrimonio de la Humanidad, en el XIII Aniversario del Centro de Saberes Africanos

La presencia de Belarus en Africa (Ensayo)

Argentina. Un vuelco inesperado ElMundoEnVenezuela 07-02-2024

En el Mapa: África, la esclavitud, el reparto territorial, la independencia y la diáspora (Documentales)

13 años del Centro de Saberes Africanos, Americanos y Caribeños, una organización con voz propia

Gabriel López Landinez, el siempre joven líder cimarrón de Yaracuy, se fue con sus ancestros

Cuba: Casa África realiza XXVIII Taller de Antropología Social Afroamericana

Presidente de Irán: Israel busca extender la inseguridad a toda la región. Conversación con el Emir de Catar

Etiopía, el país de la espiritualidad perfecta y donde un año dura 13 meses

Presidente venezolano recibe al diplomático Alex Saab tras su liberación

Venezuela y Guyana acuerdan hoja de ruta en la controversia por la Guayana Esequiba

Cancilleres de Venezuela y Guyana conversan sobre el Esequibo

XIII Aniversario del Centro de Saberes Africanos, Americanos y Caribeños #ElMundoEnVenezuela 31-01-2024

El Referendum por nuestra Guayana Esequiba #ElMundoEnVenezuela 06-12-2023

La Commonwealth y la CARICOM y su posición parcializada en la controversia Venezuela-Guyana

2do Diploma de Altos Estudios sobre Egipto. Proceso de inscripciones

Los pueblos del Esequibo. Con Erick Gutiérrez García #ElMundoEnVenezuela 29-11-2023

Elecciones en Argentina. La CIJ y el Esequibo. Con Pablo Moctezuma y Olga Alvarez #ElMundoEnVenezuela 22-11-2023

Historia de las agresiones a los pueblos del mundo. Conferencia con Pablo Moctezuma en el Centro de Saberes Africanos

«El poder de nombrar y renombrar», nuevo libro de Reinaldo Bolívar, presentado en la FILVEN2023

Programa Especial El Esequibo. Invitado especial Diputado Edgardo Ramírez

La reacción de Guyana por el referendo sobre la Guayana Esequiba de Venezuela #ElMundoEnVenezuela 01-11-2023

El empoderamiento de la mujer africana en la política: Un camino hacia la igualdad

Diplomado en Religiones y Espiritualidades: Inscripciones abiertas

Elecciones en Argentina #ElMundoEnVenezuela 25-10-2023

La leyenda del chipo que ocasionó el derribo miles de casas de bahareque en Venezuela

La Causa Palestina. Invitado Omar Hassam #ElMundoEnVenezuela 18-10-2023

Seminario sobre historia política y jurídica de la Guayana Esequiba. Con el constitucionalista Juan Carlos Mendoza

Seminario sobre historia política y jurídica de la Guayana Esequiba. Centro de Saberes Africanos

El Esequibo: La controversia Venezuela-Guyana es por la delimitación de la frontera. El laudo no es válido

¨El Esequibo herencia eterna de Venezuela” Con el Diputado Edgardo Ramírez #ElMundoEnVenezuela 27-09-2023

250 años de la Negra Matea, la Primera Maestra de Simón Bolívar, un símbolo de unidad de África y Nuestra América

Chile. 50 años sin Salvador Allende #ElMundoEnVenezuela 20-09-2023

El G20 y los BRICS #ElMundoEnVenezuela 13-09-2023

Níger, Gabón y los BRICS #ElMundoEnVenezuela 06-09-2023

Fuerzas militares de Gabón nombran a un nuevo Jefe de Estado provisional (Video)

¿Qué caracteriza a los nuevos países BRICS? ¿Cómo queda África en este grupo económico?

Níger: avión francés habría atacado a la Guardia Nacional

El mundo árabe y su inclusión en la pluralidad mundial #ElMundoEnVenezuela 23-08-2023

Foro sobre situación en Níger y post cumbre África-Rusia. En el Centro de Saberes Africanos, Americanos y Caribeños

Golpes, rebeliones y cumbres ¿Hacia dónde va África Occidental? (Análisis de Reinaldo Bolívar)

Inició el Diploma de Altos Estudios sobre Egipto, en Venezuela

Desde la revolución de los Taínos hasta la creación del CARICOM. #ElMundoEnVenezuela 02-08-2023

20 años con El Mundo en Venezuela #ElMundoEnVenezuela 26-07-2023

Palestina. Cumbre de BRICS llama a establecer Estado palestino independiente

III Cumbre UE-CELAC #ElMundoEnVenezuela 19-07-2023

Panorama electoral en Guatemala #ElMundoEnVenezuela 12-07-2023

50 años CARICOM. Situación en Rusia #ElMundoEnVenezuela 28-06-2023

Rusia: El Kremlin revela las condiciones del acuerdo con el grupo Wagner

CARICOM cumple 50 Años. Realizarán Semana del Caribe en su honor

Panorama electoral y político en Ecuador y Colombia #ElMundoEnVenezuela 21-06-2023

Víspera de San Juan Bautista en el Centro de Saberes Africanos. Viernes, 3:00 PM

Restablecimiento de relaciones Arabia Saudita-Irán: la dramática reconfiguración del mapa político en Asia Occidental

La política exterior de Irán #ElMundoEnVenezuela 14-06-2023

Extendido el tiempo de la Expo Venta y Gastronomía “Semana de África” 10AM a 4PM

Cumbre de #UNASUR. Elecciones en España y Turquía #ElMundoEnVenezuela 31-05-2023

El día mundial de África #ElMundoEnVenezuela 24-05-2023

Temporada de CINE NEGRO: EMPEROR el 26 de mayo en Gradillas

Expo Venta y Gastronomía “Semana de África” 25 al 31 de Mayo 2023

¿Qué bibliografía puedes hallar en Centro de Saberes Africanos Americanos y Caribeños?

Panorama Electoral en Türkiye #ElMundoEnVenezuela 17-05-2023

Nuevas graduaciones en el Centro de Saberes Africanos, Americanos y Caribeños. Este 17 de mayo.

Dia de la Afrovenezolanidad. Rebelión de Jose Leonardo Chirino #ElMundoEnVenezuela 10-05-2023

Embajador de México en Venezuela: Cuántas grandezas hay en nuestras raíces en Venezuela

Caracas ofrendó a la Cruz de Mayo en el Centro de Saberes Africanos, Americanos y Caribeños

Situacion política en Sudán #ElMundoEnVenezuela 03-05-2023

Este miércoles 3, Velorio de Cruz de mayo 2023 en el Centro de Saberes Africanos

19 de abril de 1810. Prof. Reinaldo Bolívar

19 de abril de 1810. Con el historiador Fidel Tupano #ElMundoEnVenezuela 19-04-2023

Miguel y Guiomar. Camino de Libertades #ElMundoEnVenezuela 14-04-2023

Diplomado Caribe Insular en 2023. IX Cohorte

Diplomado Saberes Africanos en 2023. XI Cohorte

Protestas en Francia e Israel #ElMundoEnVenezuela 29-03-2023

Crisis Financiera en EE. UU. Repercusiones. Con Martín Pulgar #ElMundoEnVenezuela 22-03-2023

Personalidades de la República Democrática del Congo y Guinea Bissau visitan Centro de Saberes Africanos

Embajadora de Sudáfrica: Continuaremos trabajando con el Centro de Saberes Africanos

52 Sesión de Derechos Humanos de la ONU #ElMundoEnVenezuela 01-03-2023

Situación Post-Terremoto en Siria y Turkiye #ElMundoEnVenezuela 15-02-2023

Los estadios más grandes de Nuestra América, dos en Venezuela

Cumbre de la CELAC #ElMundoEnVenezuela 25-01-2023

Actualidad del conflicto Rusia-Ucrania-OTAN #ElMundoEnVenezuela 18-01-2023

El Golpe de Estado contra Pedro Castillo #ElMundoEnVenezuela 11-01-2023

Brasil: Controlan Golpe de Estado contra Lula Da Silva. Desmantelados campamentos bolsonaristas

Discurso completo de Lula da Silva: Ninguna nación se ha levantado ni puede levantarse sobre la miseria de su pueblo

En 2054, una de cada cuatro personas será africana, y en 2100, una de cada tres

Pelé hizo universal al fútbol

Qué es el ‘dólar criminal’ y por qué causa nuevas preocupaciones a la economía venezolana – Orlando Rangel

Saludo de Navidad desde #ElMundoEnVenezuela

Argentina gana a Francia en los penaltis en una final del Mundial agónica (+Video)

El Golpe de Estado contra Pedro Castillo #ElMundoEnVenezuela 14-12-2022

Golpe contra Castillo: Colombia, México, Argentina y Bolivia exhortan a las instituciones peruanas a respetar la voluntad electoral

Pedro Castillo representó a un Gobierno Popular, Democrático y Progresista. Pagó por eso

Izquierda latinoamericana se solidariza con Cristina Fernández

Qatar 2022: El Mundial de las polémicas #ElMundoEnVenezuela 07-12-2022

Norma Romero, dejó su huella y su sonrisa en los afro de Venezuela

Mensaje del Día Mundial del Sida de 2022, pronunciado por la Directora Ejecutiva de ONUSIDA, Winnie Byanyima

Hablan los ponentes II del VI Congreso Internacional de Saberes Africanos Americanos y Caribeños #ElMundoEnVenezuela 30-11-2022

Déclaration finale du VIe Congrès international des Savoirs africains, américains et caribéens

Hablan los ponentes del VI Congreso Internacional de Saberes Africanos Americanos y Caribeños #ElMundoEnVenezuela 23-11-2022

Centro Massarat de Estudios Filosóficos y Humanistas de Túnez y el Centro de Saberes Africanos de Venezuela firman acuerdo de colaboración

Con declaración contra el imperialismo y por la paz concluye VI Congreso de Saberes Africanos, Americanos y Caribeños

Presentaciones Digitales. VI Congreso Saberes Africanos, Americanos y Caribeños #17Nov

Tendencias Políticas en el Sur Globalizante. VI Congreso Saberes Africanos, Americanos y Caribeños #17Nov

Conflictos Actuales en el Sur Globalizante. VI Congreso Saberes Africanos, Americanos y Caribeños

Las elecciones parlamentarias en EEUU. Invitado: Wilmer Depablo #ElMundoEnVenezuela 09-11-2022

Kamel Hedjazi en el Centro de Saberes: Estoy orgulloso de visitar este lugar

El triunfo de Lula y la visita de Petro a Venezuela #ElMundoEnVenezuela 02-11-2022

Programación: VI Congreso Internacional de Saberes Africanos Americanos y Caribeños

Elecciones en Brasil #ElMundoEnVenezuela 26-10-2022

Crisis Económica Mundial #EMV 19-10-2022

VI Congreso Internacional de Saberes Africanos Americanos y Caribeños. Programación e inscripción

La poesía de Agostinho Neto es un canto de esperanza para África

100 Años del Natalicio de Agostinho Neto, celebraran en Caracas. Harán recital con su poesía y música de Angola

100 Años de Agostinho Neto Fundador de Angola en Libertad #EMV 14-09-2022

La ONU elige a su nuevo Alto Comisionado para los Derechos Humanos

Situación Política de #Chile. invitado: Periodista Marcel Roo #EMV 07-09-2022

Referéndum en Chile #ElMundoEnVenezuela 31-08-2022

Golpe judicial en Argentina y Perú #ElMundoEnVenezuela 17-08-2022

Cambio climatico: consecuencias en Europa #ElMundoEnVenezuela 17-08-2022

#MADERA. Háblame Afro 20-08-2022

#Colombia. Háblame Afro 13-08-2022

Petro, Francia y Bolívar en Colombia #ElMundoEnVenezuela 10-08-2022

Incendio en Matanzas Cuba, continúan los trabajos de control. Se aviva la solidaridad mundial

19 años de #ElMundoEnVenezuela programa Nro 700 27-07-2022

Simón Bolívar a 239 años de su nacimiento. Programa Especial

La negra #FranciaMarquez. Háblame Afro 09-07-2022

VI Congreso Internacional de Saberes Africanos, Americanos y Caribeños. Convocatoria

Convocan al VI Congreso Internacional de Saberes Africanos, Americanos y Caribeños, dedicado a la conflictividad y política en los países del Sur

El papel del sur global en las actuales relaciones internacionales. África, Asia y Nuestra América

#SriLanka De la riqueza a la quiebra. El Mundo en Venezuela. 13-07-2022

Las nuevas repúblicas independientes en el mundo actual . El Mundo en Venezuela. 06-07-2022

Juramentan Comisión Promotora para llevar a Miguel y Guiomar de Buría al Panteón Nacional

Situación en #Ecuador. El Mundo en Venezuela. 29-06-2022

San Juan Bautista está en la Esquina de Gradillas de Caracas

Postgrados y doctorado sobre África, Caribe y Sur Global aprueba el Centro de Saberes Africanos, Americanos y Caribeños

Solsticio de verano con la Cruz de Mayo y San Juan Bautista. 21 de junio

#GiraEurasiaticaAfricana del Presidente Nicolás Maduro 2022. El Mundo en Venezuela. 15-06-2022

Saberes Africanos inicia su décimo diplomado, único en Venezuela

¿Américas o América?. Conversan Alí Ramón Rojas y Reinaldo Bolívar. EMV. 08-06-2022

#Colombia en la encrucijada. El Mundo en Venezuela. 01-06-2022

3er Congreso #Afrovenezolano. Háblame Afro 28-05-2022

La #Afrovenezolanidad en el Zulia, Aragua y Monagas. El Mundo en Venezuela. 25-05-2022

La expansión de la #OTAN en #Europa. El Mundo en Venezuela. 18-05-2022

Conozca los cambios que anunció Maduro en su gabinete ministerial

Nigeria y Marruecos construirán el gasoducto marino más largo del mundo, que atravesará 11 países

Mes de la africanidad: Programación del Centro de Saberes incluye el II Seminario sobre Cultura e Historia de Guinea Ecuatorial

¿Hacia dónde va la #CumbreDeLasAmericas?. El Mundo en Venezuela. 11-05-2022

¡Viva la Patria! Homenaje a Aristóbulo Isturiz. Háblame Afro 30-04-2022

La Cruz de Mayo es una maravillosa resurrección de las esperanzas

Centro de Saberes invita a su Tercer Velorio de Cruz de Mayo: Martes 3, a las 3 PM

#Nicaragua y la #OEA. El Mundo en Venezuela. 27-04-2022

#Argentina, #Ecuador y la #CELAC. El Mundo en Venezuela. 20-04-2022

En #Turiamo soplan vientos de cambio. Háblame Afro 02-04-2022

ONU suspende a Rusia del Consejo de Derechos Humanos: A Venezuela no se le permitió votar (+video Moncada)

Asamblea General suspende a Rusia del Consejo de DD.HH. de ONU

Diplomados en 2022

Diplomados 2022

Las agresiones deportivas a #Rusia. El Mundo en Venezuela. 06-04-2022

Embajador de Sudáfrica en Venezuela se despidió del Centro de Saberes Africanos, Americanos y Caribeños

AFROAMIGA participa en la Atención integral al bebé en Venezuela

Benín: Ex primer ministro Lionel Zinsou: «Los rusos fueron los únicos europeos que descolonizaron el continente africano»

Morbo, militarismo digital y falsedad: ¿Cómo es la guerra 3.0 que se vive en redes?

El #SaharaOccidental, tierra Saharaui. El Mundo en Venezuela. 23-03-2022

#GuerraPsicológica: Youtube censura el documental de Oliver Stone ‘Ucrania en llamas’ (+video)

Situación Política en #México: el futuro de #AMLO. El Mundo en Venezuela. 16-03-2022

El Carnaval de #ElCallao. Háblame Afro 26-02-2022

Chile ¿Una nueva etapa?. El Mundo en Venezuela. 09-03-2022

Primer monumento mundial a los infantes Simón y Matea Bolívar se erigió en Guárico

Rusia vs OTAN: El conflicto ucraniano. El Mundo en Venezuela. 02-03-2022

¿Quieres hablar de Ucrania? Claves para entender el conflicto

#BobMarley un poco de Cultura Reggae. Háblame Afro 19-02-2022

La OTAN, amenaza permanente en Europa y Asia. EMV 16-02-2022

Oigan mi palabra. Háblame Afro 05-02-2022

Personajes y un poco de Cultura Yoruba. Háblame Afro 29-01-2022

Argentina y el FMI. El Mundo en Venezuela. 02-02-2022

Situación en Honduras. El Mundo en Venezuela. 26-01-2022

Ajé San Benito Ajé. Háblame Afro 15-01-2022

Promueven proyecto cultural de restauración del paseo Negra Matea en Guárico

Los líderes de la OTSC condenan «un intento de golpe de Estado» en Kazajistán

Argentina marca nuevo récord de casos de la Covid-19 en 24 horas

¡Alerta!: Somalia, en camino a caer en manos de Al-Shabab

El primer ministro de unidad de Libia retoma sus funciones y promete ceder sus competencias a una autoridad electa

Aumenta a 21 cifra de muertos por inundaciones en Bahía, Brasil

Barbados convoca a históricas elecciones para el 19 de enero próximo

Cancelan casi 8.000 vuelos esta semana por la variante ómicron

Los libios reaccionan al aplazamiento de las elecciones presidenciales

Ministerio de Salud ruso registra fármaco anticovid MIR-19

ONU indica que 73 defensores de DD.HH. han sido asesinados en Colombia

El Parlamento libio ve «imposible» celebrar elecciones el 24

Los ataques aéreos matan al menos a 28 personas en la región de Tigray en Etiopía

Consejo de Seguridad de la ONU discute situación en Palestina

Los acontecimientos que marcaron el año 2021. El Mundo en Venezuela. 22-12-2021

Ataques armados en Nigeria se saldan con 38 civiles muertos

Elecciones Chile 2021: Boric logra un contundente triunfo sobre Kast y es el presidente electo del país

Kazajistán. Primer año de gobierno de Biden. El Mundo en Venezuela. 19-01-2022

La festividad de San Juan Bautista 18-12-2021

Huawei invierte en centros de datos en África

Sacha Llorenti: ALBA-TCP es el corazón de la integración latinoamericana y caribeña

América registra más de 2,3 millones de muertes el COVID19

Hombres armados atacan sedes del Gobierno Nacional de Libia, en Trípoli

Se retrasa la formación de un Gobierno de transición en Sudán por las consultas de una nueva declaración política

Unesco declara patrimonio fiesta de San Juan Bautista en Venezuela
“San Juan Bautista y la identidad venezolana” Invitados Gerónimo Sánchez y Meiby Ugueto. EMV. 15-12-2021

Pdtes. de Bolivia y Nicaragua arriban a Cuba para XX Cumbre del ALBA-TCP

Libios en Trípoli y Bengasi expresan esperanza y preocupación por la próxima votación

Rusia alerta de una “respuesta militar” a las provocaciones de OTAN

Primer grupo de la caravana migrantes llega a Ciudad de México

ALBA-TCP ratificará unidad regional durante Cumbre en Cuba

El principal general de Sudán, Al-Burhan, advierte contra la interferencia extranjera

Pdte. de Ecuador rechaza acudir a parlamento por Pandora Papers

Cepal estima alza de exportaciones para América Latina en 2021

El líder de la oposición de Gambia, Ousainou Darboe, pide calma tras los resultados de las elecciones

Un tribunal libio restablece la candidatura de Jalifa Haftar a las elecciones presidenciales

La Unión Africana pide levantamiento de las prohibiciones de vuelos a África por variante ómicron

OMS recela de vacunación obligatoria para enfrentar la Covid-19

Situación en Perú: La espada de la vacancia. El Mundo en Venezuela. 08-12-2021

Feliz navidad y venturoso año 2022

Changó. Háblame AFRO 04-12-2021

Talibanes aprueban decreto sobre derechos de mujeres afganas

Grupo de Puebla alerta por estrategia global contra movimientos progresistas

Nuevas protestas contra la junta militar en Sudán dejaron decenas de heridos

OMS inicia camino para tratado internacional sobre pandemias

«No es que sea terrible ómicron, es que tienen abandonados a los pobres del mundo»: López Obrador critica la gestión de Covax en África

China y África consolidan relaciones bilaterales

La UNESCO celebra la Semana Africana bajo el lema Arte, Cultura y Patrimonio

Barbados de Monarquía a República. El Mundo en Venezuela. 01-12-2021

Sudáfrica decepcionada con la UE por la prohibición de viajar

Barbados se alista para ser la república más joven del mundo

Centro de Saberes Africanos egresó cuatro nuevas promociones de diplomados en Venezuela

Arrullos. Háblame AFRO 27-11-2021

Un tribunal militar de Libia condena a muerte al general Hafter, candidato en las elecciones presidenciales

Atentado en manifestación feminista en Sonora, México, deja tres fallecidos

Los presidentes de Kenia y Sudáfrica piden la paz en África

Venezolana Yulimar Rojas finalista al premio de Mejor Atleta del Año

El primer ministro de Etiopía, Abiy Ahmed, promete liderar tropas en la guerra contra los rebeldes

Marcha por la Patria y la Democracia inicia en Caracollo, Bolivia

Elecciones en Honduras. El Mundo en Venezuela. 24-11-2021

CNE venezolano: PSUV obtiene 20 de las 23 Gobernaciones en comicios regionales

El primer ministro de Sudán, Hamdok, regresa al cargo en medio de protestas

La CEDEAO impone sanciones a más de 150 miembros del gobierno de Malí

Corte Suprema de Nicaragua respalda posible salida de la OEA

MAS alerta que sigue vigente amenaza de ‘segundo golpe’ en Bolivia

OMC advierte que el mundo se enfrentará a más desastres naturales

Las elecciones en Chile, entre la izquierda y la ultraderecha. Con Marcel Roo. EMV 17-11-2021

Burundi: la protección de los lagos del norte ya está dando frutos

Argentina inicia etapa centrada en diálogo con la oposición

Argentina entra en la última jornada de campaña electoral

Benin recibe los tesoros entregados por Francia

La corporación occidental va por Etiopía

Ejército de la República Democrática del Congo dice que rebeldes atacan base oriental

La C.P.I. / Etiopía. El Mundo en Venezuela. 10-11-2021

El líder golpista defiende el golpe en Sudán y resalta que no será parte del Gobierno tras la transición

ONU advierte sobre aumento de hambruna en el mundo

Noticias Etiopía conmemora el primer aniversario del conflicto de Tigray

Senado de Bolivia aprueba Plan de Desarrollo Económico y Social

Hombres armados secuestran a personal universitario y estudiantes en Abuja, Nigeria

Presidente de Chile pedirá al Congreso extender estado de emergencia

Etiopía declara emergencia nacional a medida que avanzan los rebeldes

COP26 gestiona acuerdo para frenar y revertir deforestación

Situación electoral en Nuestra América. EMV. 03-11-2021

Tensa calma en Sudán tras la gran protesta contra el golpe militar

António Guterres llama a disminuir temperatura global en la COP26

El Padre Cantor Alí Primera. Háblame AFRO 30-10-2021

Consejo de Seguridad pide restablecer el Gobierno en Sudán

Reunión de ministros de Asuntos Exteriores de la UA y la UE

Seminario Arte Africano (Máscaras)

Con Curiepe Solidario. Boletín 27

Inicia juicio que podría revocar boleta electoral de Bolsonaro

El BAD lanza nueva estrategia para una infraestructura sanitaria de calidad en África

Arranca en Ecuador nueva jornada de movilizaciones contra el Gobierno

Golpe de estado en Sudán. El Mundo en Venezuela. 27-10-2021

Sudán: Nuevo golpe de estado.

Curiepe, Venezuela: 320 adolescentes se prepararon en Habilidades para la vida (videos)

Somalia: Farmajo y Roble acuerdan ‘acelerar’ proceso electoral

Gobierno saliente de Cabo Verde entregó a Saab antes del regreso del socialismo al poder

Pdte. Ecuador se rehúsa otra vez a fiscalización legislativa

Comisión legislativa acusa a Bolsonaro de crímenes de lesa humanidad

Malí pide a los líderes musulmanes que negocien con la afiliada de al Qaeda

Con Curiepe Solidario. Boletín 26

Diez años desde la muerte de Gadafi, la seguridad de Libia está en juego

Presidente de Ecuador decreta estado de excepción por 60 días

Turquía promete incrementar los lazos comerciales con África

Con Curiepe Solidario. Boletín 25

NO AL RACISMO. Háblame AFRO 16-10-2021

Cumbre de lideresas indígenas abre sesiones en Lima, Perú

Con Curiepe Solidario. Boletín 24

Oposición parlamentaria chilena ingresa acusación contra Piñera

Cabo Verde se prepara para las elecciones presidenciales del 17 de octubre

Desafíos en derechos de los pueblos indígenas en Latinoamérica

El presidente de Túnez nombra nuevo gobierno por decreto

Las actuales luchas indígenas en Nuestra América. El Mundo en Venezuela. 13-10-2021

La descolonización de la Memoria Histórica en Nuestra América, Con Reinaldo Bolívar

Cumbre ministerial por el 60 aniversario del Mnoal comienza en Serbia

Abdulrazak Gurnah, Premio Nobel de Literatura 2021

Con Curiepe Solidario. Boletín 23

Sierra Leona abolió formalmente la pena de muerte

El mundo cuenta ya con una vacuna para la malaria, la primera contra una enfermedad parasitaria

El Curiepero N° 8

El Curiepero N° 7

Se firmó un memorando de entendimiento sobre cooperación para el desarrollo entre la Comisión de la Unión Africana y la Agencia de Cooperación y Coordinación de Turquía

Con Curiepe Solidario. Boletín 22

Argentina registra 50% de su población vacunada contra la Covid

África muestra 50 prometedores innovaciones en educación

Pueblos originarios de Ecuador activan derecho a la resistencia

Anuncian apertura comercial en la frontera entre Venezuela y Colombia a partir de este martes

Aumentan las tensiones diplomáticas entre Francia y Argelia

ONU insta a garantizar derechos humanos de migrantes haitianos

Invitan al Foro las relaciones de cooperación entre África y Nuestra América | Youtube

Denuncian que 12 venezolanos han muerto en la frontera chilena

Con Curiepe Solidario. Boletín 21

Con Curiepe Solidario. Boletín 20

Presidente de Túnez nombra primera ministra

Se agudiza situación de inestabilidad política en Haití

ONU alertó que amenaza nuclear sigue como un peligro presente

La junta de Guinea presenta la ‘carta’ para la transición civil

Las elecciones de Malí podrían posponerse, dice el primer ministro

Mil desaciertos del gobierno de Bolsonaro en Brasil

Grupo armado masacra civiles en República Democrática del Congo

Jóvenes en el mundo se manifiestan contra el cambio climático

Anuncia Ejército saharaui acciones contra tropas de Marruecos

África, América Latina y el Caribe unen fuerzas para impulsar la cooperación

Presidentes latinoamericanos intervendrán en debate general en ONU

Muere a los 80 años Abdelkader Bensalá, presidente interino de Argelia tras la dimisión de Buteflika

Asesinan en un día a cinco líderes sociales en Colombia

Golpe fallido en Sudán: el gobierno culpa a los elementos pro-Bashir

De la Cumbre de la CELAC a la Asamblea de la ONU. EMV 22-09-2021

Un pequeño país africano es el único del mundo que cumple con los objetivos para frenar el cambio climático

Comienza 59 Consejo Directivo de OPS enfocado en pandemia de Covid-19

Fallece el revolucionario Abdelaziz Bouteflika, exitoso presidente de Argelia de 1999 a 2019

Celac por recuperación económica posCovid-19

África occidental recurre a las sanciones mientras los golpistas consolidan el poder en Guinea y Malí

La CEDEAO se reunirá de nuevo sobre Guinea mientras la junta mantiene más conversaciones de « transición ‘

Pdte. de México encabeza ceremonia del Grito de Independencia

San Agustín el barrio. Háblame AFRO 11-09-2021

Misión de la Cedeao llega a Guinea para hablar con los golpistas

Pandemia de Covid-19 destruyó ocupaciones informales en Latinoamérica

Centro de Saberes, Embajadas de Sudáfrica y San Vicente Las Granadinas organizan foro sobre relaciones América-África

Guinea: la normalidad vuelve a Conakry golpeada por el golpe

Partidos políticos brasileños evalúan destitución de Bolsonaro

Aspirante opositor ganó comicios en Santo Tomé y Príncipe

Anuncian movilizaciones en Ecuador contra Gobierno de Lasso

López Obrador y la integración bolivariana. El Mundo en Venezuela. 08-09-2021

Adoptó Argelia plan de reactivación de su diplomacia

¿Qué son las elecciones PASO y qué se votará en Argentina?

Guinea (Conakri): Golpe de Estado dan las Fuerzas Especiales de Élite

Con Curiepe Solidario. Boletín 19

Los vecinos de Libia piden la salida de los combatientes extranjeros

Sube a 42 la cifra de muertos por lluvias en el noreste de EE.UU.

Asamblea Nacional declara el 31 de agosto como Día Nacional de los Afrodescendientes

Anuncian hallazgo petrolífero en plataforma marina de Costa de Marfil

Senegal y la Comisión Europea proyectan la apertura de una planta de fabricación de vacunas

Foros sobre varios temas en celebración día de los afrodescendientes

Sudán y Chad acuerdan reforzar la seguridad y luchar contra las amenazas terroristas transfronterizas

Haití sin acuerdo político y asolado por crisis humanitaria

Un Panorama Internacional. El Mundo en Venezuela. 01-09-2021

Abordan en ONU situación en Medio Oriente y Palestina

Los huracanes Ida y Nora dejan al menos dos muertos y severos daños

HAITÍ. Háblame AFRO 28-08-2021

África se lanza a una carrera para producir sus propias vacunas contra la covid-19 en dos años

Aumenta a 95 la cifra de personas muertas en Kabul tras atentados del Daesh

Venezuela: Embajada de Sudáfrica y Centro de Saberes conversan sobre las relaciones África-América

Comité del Paro de Colombia retoma marchas contra Iván Duque

Inaugurarán en Angola tres fábricas para corte de diamantes

Argelia rompe relaciones con Marruecos por “acciones hostiles”

Ghana: el festival de artes callejeras Chale Wote 2021 se realiza en medio de restricciones de covid

Paso de huracán Grace por México deja saldo de 11 muertos

Presidente tunecino prorroga suspensión del Parlamento

Con Curiepe Solidario. Boletín 18

Con Curiepe Solidario. Boletín 17

Con Curiepe Solidario. Boletín 16

Con Curiepe Solidario. Boletín 15

Con Curiepe Solidario. Boletín 14

Con Curiepe Solidario. Boletín 13

ONU alerta que 235 millones de personas precisan ayuda humanitaria

Exportaciones egipcias crecen un 22 por ciento en 2021

Afroreligiosidad. Háblame AFRO 14-08-2021

El Curiepero N° 6

El Curiepero N° 5

Ébola: Guinea y Costa de Marfil luchan por vacunar y aislar contactos

Gobierno de Ecuador insiste en diálogo con indígenas

Expertos confirmaron masacres por golpe de Estado de 2019 en Bolivia

Burkina Faso: 47 muertos en nuevo ataque yihadista en el norte

Talibanes anuncian que impondrán un gobierno islámico en Afganistán

Cumbre sudafricana: el presidente de Malawi impulsa la igualdad de acceso a las vacunas

San Vicente y Granadinas rechaza papel de OEA contra la región

Afganos lanzan campaña para atrapar a fugitivo presidente Qani

Afganistán. El Mundo en Venezuela. 18-08-2021

Hichilema gana las elecciones presidenciales en Zambia

Más de 1.200 personas mueren tras un terremoto de magnitud 7,2 que azotó Haití

Talibanes toman la segunda ciudad más importante de Afganistán

Insurgentes tratan de obstaculizar elecciones en Somalia

Argelia registra más de 60 fallecidos por incendios forestales

Haití programó elecciones para el 7 de noviembre

Zambia se prepara para las elecciones nacionales este jueves

Cancilleres analizarán ruta migratoria irregular en América

Rechazan desfile militar en Brasil con participación de Bolsonaro

Revelan cooperación israelí-saudí en llevar a cabo “golpe” en Túnez

Crisis del Grupo de Lima. Con el Dr. Franklin González. EMV 11-08-2021

Egipto construye 14 plantas desalinizadoras

Campesinos guatemaltecos convocan a Paro Nacional

Ataques causan 30 muertos en Burkina Faso

¿Cómo fue el proceso de independencia de Jamaica?

Reinaldo Bolívar presentó estudio sobre la descolonización de la Memoria Histórica en Venezuela

Líbano denunciará en ONU las violaciones de Israel

Corte Suprema de Brasil anuncia investigación contra Bolsonaro

Sudán da el primer paso para unirse a la corte internacional

Humanidad lejos de alcanzar acceso al agua para todos

Establecen en ONU Foro Permanente de los Afrodescendientes

Seyed Ebrahim Raisi toma juramento como nuevo presidente de Irán

Sudán del Sur jura nuevo parlamento prometido en virtud del acuerdo de paz

En un salto Venezuela se viste de Oro con Yulimar. La Reina del Salto Triple

Mujer Afrovenezolana. Háblame AFRO 31-07-2021

Nuevo presidente peruano juramenta a su gabinete de gobierno

Países de agrupación africana iniciaron reunión de alto nivel

Rechazan proyecto para aplicar la ley israelí en zonas palestinas

Guatemaltecos se movilizan en rechazo al presidente Giammattei

Medio Oriente y Palestina ocupan debate en ONU

Declaran calamidad en Necoclí, Colombia, por crisis migratoria

¿Cuáles serán los retos de Pedro Castillo en Perú?

Empresa petrolera confirma solicitud para financiar golpe de Estado en Madagascar

El presidente de Túnez destituye al primer ministro en medio de la tensión política

Pdte. electo de Perú anuncia que devengará sueldo de maestro

Somalia retrasa elecciones clave sobre nombres de candidatos

XVIII Aniversario de El Mundo en Venezuela. 28-07-2021

La educación del Niño Simón. Conversación con Reinaldo Bolívar

Ascienden a 51 las muertes por inundaciones en Henan, China

Policía de Madagascar arresta sospechosos de planear magnicidio

«Apertura de nueva terminal petrolera frustra sanciones de EEUU»

Autoridades controlan amotinamientos en dos prisiones de Ecuador

El Pentágono realiza su primer bombardeo en Somalia bajo la administración Biden

Asamblea General de ONU rinde tributo a Nelson Mandela

Situación post electoral en Perú. El Mundo en Venezuela 21-07-2021

Gabón es el primer país africano en ser recompensado por reducir el CO2

Policía de Haití emite orden de captura contra empresario vinculado al plan de magnicidio

Curiepe. Háblame AFRO 17-07-2021

Los líderes africanos buscan $ 100 mil millones del fondo del Banco Mundial para financiar la recuperación económica

Policía haitiana afirma que el magnicidio de Moïse fue planeado en República Dominicana

Candidatos presidenciales de Chile buscan apoyo para primarias

Algunas naciones africanas tienen dudas sobre el acuerdo de reforma fiscal global de la OCDE

Rompe África barreras de muertes y contagios con Covid-19

Bolsonaro es hospitalizado en Brasilia por dolor abdominal

Pdte. de Argentina pide terminar los bloqueos contra Cuba y Venezuela

Mujeres agricultoras se vuelven orgánicas en Costa de Marfil

Bloque de habla portuguesa celebra conferencia en Angola

Policía haitiana arresta al presunto autor intelectual del magnicidio de Jovenel Moïse

El golpe mediatico a Cuba. Con Edgardo Ramírez. El Mundo en Venezuela 14-07-2021

Con Curiepe Solidario. Boletín 12

Recordando, Argelia Laya: Nuestra Causa

Argelia Laya. Háblame AFRO 10-07-2021

Salva Kiir de Sudán del Sur promete no volver a la guerra en su discurso de independencia

Irán: EEUU comete crimen de guerra; antepone intereses a la salud

Botswana rompe su propio récord de diamantes con un nuevo descubrimiento

Critican fallo judicial sobre ley racista en Israel

Primer ministro de Somalia aborda disenso con Jubalandia

Asesinan a tiros al presidente de Haití, Jovenel Moise

Situación en Chile. El Mundo en Venezuela 07-07-2021

Convocan paro en Perú para exigir proclamación de Castillo

Primer ministro interino de Líbano emite llamamiento dramático

Con Curiepe Solidario. Boletín 11

Centro de Saberes Africanos, Americanos y Caribeños recibió visita de delegados sudafricanos

Los pormenores del 5 de julio de 1811. Conversación con Reinaldo Bolívar

Con Curiepe Solidario. Boletín 7

ONU advierte sobre el aumento de asesinatos a líderes sociales y excombatientes en Colombia

Un empresario ugandés convierte los vertederos en una empresa rentable

Embajador designado de Mauritania ante Venezuela visita Centro de Saberes Africanos, Americanos y Caribeños

Mauritania se beneficia de nuevo del alivio de deuda consensuado por el G20

Vislumbran en ONU oportunidades para acuerdo nuclear con Irán

Somalia celebrará elecciones presidenciales en octubre venidero

Avanzan consultas para reforma indígena y afromexicana

Etiopía anuncia alto el fuego en Tigray mientras los rebeldes toman la capital regional

Siria condena ataque de EEUU contra su territorio

Cumbre Extraordinaria del ALBA. El Mundo en Venezuela 30-06-2021

Bloqueo a la admisión de la República Democrática del Congo en la Comunidad de África Oriental

Colombia llega a dos meses de protestas y movilizaciones sociales

China y Rusia prorrogan tratado de buena vecindad y cooperación

Somos libres, escribimos en un país libre y no nos proponemos engañar al público. 27 de junio, 1818

Santos de Negros. Háblame AFRO 26-06-2021

Mozambique celebra aniversario 46 de su independencia

ALBA-TCP sella compromiso con la integración latinoamericana y caribeña

El Curiepero N° 4

A 200 años de la Batalla de Carabobo Venezuela continúa en defensa de su independencia

Costa de Marfil condena a cadena perpetua al ex primer ministro Soro por planear un golpe de Estado

Apretada agenda en cumbre regional de la Unión Europea

Irán afirma que bloqueo de sitios web limita la libertad de expresión

ALBA-TCP enfrenta desafíos desde la integración y la solidaridad

Biden planea redesplegar tropas estadounidenses en Somalia

Al menos un muerto y 40 heridos deja represión del Esmad en Bogotá

China urge a UE adherirse al multilateralismo y cooperación

¿Qué pasó el día antes de la Batalla de Carabobo? REVELACIONES INÉDITAS. EMV 23-06-2021

Con Curiepe Solidario. Boletín 10

21 días de luto por el padre fundador de Zambia, Kenneth Kaunda

Debuta en formato online Festival de Chile Somos del Sur

El Curiepero N° 3

Perú: Entre el hecho consumado y los afanes golpistas

Descubren el tercer diamante más grande del mundo en Botsuana

La infancia en África entre el conflicto y la pobreza

Denuncian crímenes de Trump contra Irán

Mo Ibrahim: El acaparamiento de vacunas perjudica a África

Candidatos presidenciales en Irán centran su campaña en la economía

Grupos paramilitares retienen a ciudadanos en Norte de Santander, Colombia

Resultados electorales en Perú ¿Qué pasará?. El Mundo en Venezuela 16-06-2021

Legado africano. Háblame AFRO 12-06-2021

Con Curiepe Solidario. Boletín 9

Siria presenta pruebas del apoyo de EEUU al terrorismo

Apagón afecta a numerosos sectores de Puerto Rico

El Curiepero N° 2

Alemania rechaza los llamamientos para reparar el genocidio en Namibia

Legislativo de China aprueba ley contra sanciones internacionales

Zimbabue y el potencial de su industria del oro

Con el 99,79% de actas procesadas Pedro Castillo lidera las elecciones en Perú

Damasco condena postura trumpista de Biden: Golán es y será sirio

Crean en Somalia equipo de asesores para organizar elecciones

¿Qué hizo Muamar el Gadafi por Libia?

Conteo rápido en Perú mantiene empate, pero con ventaja para Castillo

Goita, líder golpista de Malí, jura como presidente de transición

Inician nuevos diplomados en Saberes Africanos; y en Caribe Insular

Países africanos examinarán situación de crisis en Chad

La ONU advierte sobre el empeoramiento de la situación humanitaria en la República Democrática del Congo

Denuncian nuevos actos de represión por el Esmad en Bogotá, Colombia

El Curiepero N° 1

Con Curiepe Solidario. Boletín 8

Golpes de Estado: Por qué la UA actuó con dureza con Mali pero ignoró a Chad

Foro de San Petersburgo se acerca a relaciones Rusia-Latinoamérica

Isaac Herzog es elegido como nuevo presidente de Israel

La UA suspende a Mali después del segundo golpe en 9 meses

Siria cuenta con 80 mil instalaciones industriales operativas

Caos en el Parlamento Panafricano por las elecciones del organismo continental

Duque opta por la represión contra el pueblo colombiano

¿Cómo sigue la campaña electoral a 17 días de las elecciones presidenciales en Irán?

Colombia y Perú. El Mundo en Venezuela 02-06-2021

Presentan espectacular escultura de Matea y Simoncito

Chad acusa al Ejército Centroafricano de matar a seis de sus soldados

Negociaciones estancadas entre Gobierno de Colombia y Comité del Paro

XVI Semana Mundial de África en Venezuela. 29-05-2021

Alemania reconoce los asesinatos coloniales en Namibia como genocidio

Comité del Paro en Colombia acusa que Gobierno de Duque se niega a firmar preacuerdo

Prevén en los próximos dos meses elecciones en Somalia

Nueva represión policial en Colombia deja decenas de heridos y detenidos

Exigen en Ecuador mantener subsidios al combustible

¿La moneda ECO de África Occidental todavía en el horizonte?

Sirios comienzan a votar en elecciones presidenciales

Anuncian lista final de los candidatos a la Presidencia de Irán

Condenan detenciones en Mali de presidente y primer ministro

Diez cosas que celebrar en el Día de África

Conversando con una familia venezolana en África. El Mundo en Venezuela 26-05-2021

Zolani Mkiva, el Poeta de África, visitó el Centro de Saberes Africanos y se reunió con Reinaldo Bolívar

Con Curiepe Solidario. Boletín 6

Afrozulianidad. Háblame AFRO. 22-05-2021

Fundación Afroamiga implementa programas solidarios en Curiepe, Venezuela

Fundación Afroamiga implementa programas solidarios en Curiepe, Venezuela

Consejo Supremo Económico Euroasiático profundiza proceso integrador

Elecciones legislativas en Argelia: Comienzan las campañas

Comité del Paro y Gobierno colombiano avanzan en negociaciones

África solo ha recibido el 2% de las vacunas Covid mundiales, dice la ONU

Vuelve Marcha del Silencio en Uruguay por verdad y justicia

China aplazó envío de otra parte de su estación espacial

Debaten en ONU sobre paz y seguridad en África

La policía española dispara gases lacrimógenos contra los migrantes en la frontera con Marruecos

Colombianos toman las calles contra Gobierno de Duque y la brutalidad policial

Cumbre de Finanzas de África para abordar la recuperación posterior a una pandemia

Crecen presiones para que EEUU detenga agresión de Israel

Nueva jornada de movilizaciones en Bogotá y otras ciudades de Colombia

Elecciones en Chile, con Marcel Roo. El Mundo en Venezuela 19-05-2021

Elecciones de gobernadores chilenos se deciden en balotaje

Refugiados y casas blancos de los bombardeos israelíes a Gaza

Uganda construye un enlace con la línea ferroviaria de ancho estándar de Kenia

Con Curiepe Solidario. Boletín 5

Ngozi Okonjo-Iweala hará de la OMC «una organización que logre resultados»

Junta militar declara ley marcial en una ciudad de Myanmar

Palestina denuncia ataque israelí con armas químicas en Gaza

Sierra Leona en camino hacia la abolición de la pena de muerte

Advierten que Somalia enfrenta un riesgoso futuro alimentario

Escalada de tensión entre Israel y Palestina: Hamas golpea Tel Aviv, Beerseba y Lod

África condena la brutal represión israelí contra los palestinos

¡40 años después, el cantante de reggae Bob Marley aún vive!

Burundi aspira a convertirse en la potencia del bádminton

Erdogan condena violencia israelí en diálogo con líderes palestinos

Salah gana el premio Defensor del Atleta del Año en los Laureus World Sports Awards

ONU solicita a Israel que suspenda desalojos en Jerusalén Este

Con Curiepe Solidario. Boletín 4

China anuncia la «suspensión indefinida» del diálogo económico con Australia en medio del aumento de tensiones entre los dos países

Chad contra la violencia de grupos armados

Unión Africana condena terrorismo en Níger, Burkina Faso y Mali

China bajo alerta por nueva ronda de tormentas de arena

Situación en Colombia y El Salvador. El Mundo en Venezuela 05-05-2021

La India supera los 20 millones de infecciones por coronavirus

Al menos 30 muertos en ataque en el este de Burkina Faso

Conoce el origen de celebración de la Cruz de Mayo en América Latina

La junta gobernante de Chad nombra un gobierno de transición

EEUU usará compañías privadas para vigilar sus ciudadanos en Internet

Con Curiepe Solidario. Boletín 3

Un tambor para ARISTÓBULO. Háblame AFRO. 01-05-2021

El Dr. José Gregorio Hernández se convierte en el cuarto beato venezolano y el primer laico beatificado

Funcionarios de la Unión Africana llegan a Chad en medio de disturbios políticos

Argentina repudia nuevos lanzamientos de misiles en Malvinas

Atentado suicida en Somalia causa siete muertes

India rebasa los 18 millones de contagios con la Covid-19

El presidente de Somalia pide elecciones para calmar las tensiones

Cooperación económica África-Turquía, un importante foro de inversiones en África se celebrará en junio en Estambul

Parlamento japonés aprueba significativo acuerdo comercial

Se fue Aristóbulo Istúriz, el Cimarrón Mayor de Venezuela

África Central y Chad. Homenaje Póstumo Aristóbulo Istúriz. E.M.V. 28-04-2021

Chad: estallan protestas mortales a medida que aumenta la demanda de retorno del gobierno civil

Gobierno de Haití insiste en elecciones pese a inseguridad

Los somalíes huyen de Mogadiscio por temor a nuevos enfrentamientos armados

El ejército de Chad nombra primer ministro al subcampeón de las elecciones

Presidente electo de Ecuador anunciará parte de su Gabinete

Irán promete darle a Israel una «respuesta fundamental» y asegura que las medidas tomadas harán «entrar en razón» a Tel Aviv

Con Curiepe Solidario. Boletín 2

Unión Africana pide diálogo en Somalia para solventar crisis

Realizan funeral de Estado al presidente de Chad

Jordania exhorta a acción internacional para detener a Israel

La oposición de Chad critica el ‘golpe’ mientras las principales potencias callan ante la toma del poder

Supremo de Brasil discute sobre destino de acciones contra Lula

Joe Biden inaugura cumbre virtual sobre cambio climático

Policía Derek Chauvin declarado culpable por la muerte de George Floyd

Muerte de Idriss Deby: Chad se despierta con nuevos gobernantes

Cumbre Iberoamericana por frente común para conseguir vacunas

Magnicidio contra el presidente de Chad, Idriss Déby, tras ser reelegido

Extrema alerta tras nueva explosión del volcán La Soufriere

El partido gobernante de Cabo Verde retiene el poder tras ganar la votación legislativa

Los Olvidados del 19 de abril de 1810, la fecha esencial de la independencia americana

El 19 de Abril. Reinaldo Bolívar. Videoconferencia

Henry Stephen. El Rey Negro Háblame AFRO. 17-04-2021

Con Curiepe Solidario. Boletín 1

Acuerdo de Asociación UE / África-Caribe-Pacífico concluido

Abogan en Haití por gobierno de consenso

Histórica primera votación en el Congreso de los Estados Unidos para corregir los errores de la esclavitud

Expertos de ONU señalan que programa de EE.UU. viola derechos

Retoman en Brasil juicio sobre condenas anuladas a Lula

El plan de Japón de verter al mar el agua de Fukushima desata la polémica en el mundo: ¿hay motivos para preocuparse?

Presidente de Somalia firma ley ampliando su mandato

Juzgarán a expresidente de Burkina Faso por magnicidio

Religiones por la Paz abandona proceso de diálogo en Haití

El parlamento de Somalia extiende el mandato del presidente tras la disputa electoral

La Unión Africana elogia las elecciones presidenciales ‘pacíficas’ de Chad

Irán culpa a Israel por el incidente de Natanz y promete «vengarse

Autoridad electoral de Perú anuncia resultados oficiales para primera semana de mayo

Ecuador. Perú. El Mundo en Venezuela 14-04-2021

India y China celebran nuevo diálogo sobre retirada militar

Elecciones presidenciales de Djibouti: la votación comienza con calma

Reportan pérdida de 26 millones de empleos en Latinoamérica

Intensifican ataques aéreos contra el Daesh en centro de Siria

Kagame de Ruanda dice que el informe francés sobre el genocidio es «un paso importante»

Irán exige levantamiento de sanciones estadounidenses

Brasil reporta la cifra récord de 4.000 muertes por covid en un día

Detectan armas de EEUU e Israel en depósito terrorista en Siria

Unesco incentiva foro internacional para cultura de paz en África

Nota de duelo

Ecuador: Cuatro últimos días para captar apoyo clave

Irán considera buen paso diálogo entre signatarios de acuerdo nuclear

Cuarentena con Bituaya. Háblame AFRO. 03-04-2021

Pasión, muerte y resurrección del Cacique Hatuey

Rusia reanuda los vuelos con Venezuela, Alemania, Siria y otros tres países

Líbano proporcionará servicios médicos por petróleo de Iraq

TURIAMO. Parte 2. Háblame AFRO. 27-03-2021

Diplomados 2021

TURIAMO. Parte 1. Háblame AFRO. 20-03-2021

Hacia dónde va la izquierda en Nuestra América. El Mundo en Venezuela 17-03-2021

Mes de Mujeres. Háblame AFRO. 13-03-2021

Nicolás Maduro | Bicentenario de la Siembra de Juan Germán Roscio Nieves(video)

Maduro: Juan Germán Roscio es nuestro ideólogo republicano

El Primer Prócer Civil de Nuestra América. 200 años de la inmortalidad de Roscio Nieves

Sesión Solemne en Honor a Juan Germán Roscio Nieves. Lunes 8 de Marzo en Guárico

Ruta del Prócer JG Roscio Nieves al Panteón Nacional se aproxima a Caracas

Marzo de Mujeres. Háblame AFRO. 06-03-2021

A 200 años de la inmortalidad de Juan Germán Roscio Nieves. El Mundo en Venezuela 03-03-2021

Congreso Bicentenario de los Pueblos. Capítulo Afrodescendientes. Háblame AFRO. 27-02-2021

El Uali Mustafa el joven mártir, fundador y presidente de la República Saharaui

La República Saharaui lucha por su independencia. El Mundo en Venezuela 24-02-2021

Ecuador elige: derechas, izquierdas, indígenas. Un detalle a considerar.

Homenaje a Isidora Calypso Queen. Háblame AFRO. 13-02-2021

Situación en Haití. 10-02-2021

Homenaje a Bob Marley. Háblame AFRO. 06-02-2021

4 de febrero: Día de la Dignidad Nacional. Con Alí Ramón Rojas Olaya y Reinaldo Bolívar

Golpe en Miammar. Elecciones en Ecuador. 03-02-2021

Centro de Saberes Africanos, Americanos y Caribeños firma carta de hermanamiento con la Universidad UNOGA de Haití

Cultura Afro – Guillermina Ramírez. Háblame AFRO. 30-01-2021

X Aniversario del Centro de Saberes Africanos Americanos y Caribeños. 27-01-2021

X Aniversario del Centro de Saberes, una década de lucha por los pueblos del Sur

Centro de Saberes postula a Brigadas Médicas Henry Reeve al Premio Nobel de la Paz

El poder de las redes y EEUU. 20-01-2021

R. Dominicana y Venezuela en Norberto y Ángel James. Háblame AFRO 16-01-2021

Unión Europea y EEUU. 13-01-2021

Análisis del Asalto al Congreso de EEUU. Por Reinaldo Bolívar, En Pauta 08-01-2021

Asalto al Congreso: La doctrina Trump y el futuro tortuoso de los EEUU

Instalación de la Gran Asamblea Nacional 2021 con Reinaldo Bolívar 05-01-2021

23 de enero: Fraude Histórico. Con Alí Ramón Rojas Olaya y Reinaldo Bolívar 23-01-2021

La decisión de la CEDEAO es vinculante, caso ‘Alex Saab’. Reinaldo Bolívar ¡EN EXCLUSIVA!

Diciembre AFRO. Háblame AFRO 02-01-2021

Navidad y fin de año en el mundo. 23-12-2020

Navidad 2020, Año Nuevo 2021: Un mensaje de esperanzas del Centro de Saberes y AFROAMIGA

Simón Bolívar, en Las Calderas del Miedo. 17-12-2020

¿Murió Simón Bolívar abandonado, sin amigos y como un mendigo?

Situación en Colombia. Cumbre ALBA. 16-12-2020

Un balance de la campaña. Háblame AFRO 12-12-2020

08 de diciembre de 1530: Natalicio del Gran Cacique Guaicaipuro

Soberanía y elecciones en Venezuela. 09-12-2020

Homenaje a la camarada Argelia Laya. Háblame AFRO 05-12-2020

MARADONA Humano y Político 02-12-2020

Jerusalema: Todo sobre la canción en la lengua de Mandela que hace bailar y rezar al mundo (videos)

Argelia: Denuncian avalancha de ataques verbales desde Francia

200 años del Armisticio y Tratado de Regularización con Reinaldo Bolívar 27-11-2020

Guatemala. El Mundo en Venezuela 25-11-2020

GUERRA Saharaui/Marruecos. Crisis en Perú. El Mundo en Venezuela 18-11-2020

La República Árabe Saharaui declara la guerra al Reino de Marruecos

IV Conferencia CLACSO Venezuela: El Centro de Saberes presente. Viernes 13, a las 11:30 AM

Las diferencias en política exterior de los demócratas y republicanos desde 2008

David Choquehuanca: Su impactante, conmomendor e inédito discurso de toma de posesión

Crisis Presidencial en Perú. El Mundo en Venezuela 11-11-2020

IV Conferencia CLACSO Venezuela Crisis por y post pandemia: del 11 al 13 de noviembre (Programación)

El canto negro de Alí Primera, el cantor de la Patria Buena (videos)

La escuela descolonizadora de Simón Rodríguez

Elecciones EEUU. El Mundo en Venezuela 28-10-2020

Chile: ¿Por qué es histórico e inédito el plebiscito constitucional de Chile?

Bolivia. Referendo en Chile. El Mundo en Venezuela 21-10-2020

Luis Arce, del MAS, nuevo presidente de Bolivia

Elecciones en Bolivia. El Mundo en Venezuela 14-10-2020

Día de la Resistencia Indígena: Francisco Fajardo, el genocida que da nombre a la principal vía de Caracas

En el día mundial de la vista: Hay 180 millones de personas con discapacidad visual y 1000 millones sin accesos a lentes u operaciones

El Mundo en Venezuela 07-10-2020. El Consejo de los DDHH de las Naciones Unidas

El Mundo en Venezuela 30-09-2020. Nigeria, Ecuador, Armenia y Azerbaiyán

Alejandra Gonzáles y Luz Silva, un dúo insurgente

El Mundo en Venezuela 23-09-2020. ONU, entre Pandemia y Unilateralismo

Matea Bolívar: Dos Cartas inéditas y su partida de defunción

CEDEAO se reúne con golpistas de Malí para acordar bases de una transición civil

El Mundo en Venezuela 02-08-2020. Vietnam. Congreso Internacional de Educación

1973 la derecha chilena y la CIA derrocan a Salvador Allende e instauran una cruel dictadura

Yemen: un país que muere ante un mundo indiferente

Paraguay: Ejército asesina a dos niñas de 11 años, con el aplauso presidencial

África: el Covid 19 retrocede. El continente en la vanguardia mundial contra el coronavirus

Marcus Garvey, el jamaiquino que puso a África en la escena mundial

Libano hoy: La Lucha por la vida de un pueblo acechado y en dificultades (Conferenciaweb,Viernes 14/08/2020)

Teresa González la acérrima Insurgente: Renunció a su fortuna por la Patria

África y América saludan el nacimiento de la Cátedra de Mujeres Negras y Afrodescendientes del Sur Global (Videos)

«Pobre Negro», en el 136 aniversario de Rómulo Gallegos

Día de la Mujer Africana: 10 mujeres que hicieron historia (videos)

Crean Cátedra de Mujeres Negras y Afrodescendientes del Sur Global

Malí: Continúan intentos de golpe de estado

Conversación entre Roscio Nieves y Andrés Bello sobre una Biblioteca Nacional para Venezuela

Carta pública al FGR Tarek William Saab, sobre el caso Orlando Figuera

Caribe: 47 años del organismo más consolidado de América, la CARICOM

Programa El Mundo en Venezuela, conducido por Reinaldo Bolívar gana el Premio Nacional de Periodismo Aníbal Nazoa 2020 en Radio

En 1960, 17 países africanos se independizaron de Europa

Reinaldo Bolívar: La africanidad transfirió importantes tecnologías a la humanidad

Países africanos suman más de 300 mil casos de coronavirus

Estados Unidos Racismo en tiempos de Pandemia: Video Conferencia, 15 de junio de 2020, a las 15:00 Horas Venezuela

10 países africanos concentran el 80% de los casos de Coronavirus del continente

De George Floyd a la guerra total contra el sistema mundial imperante

Videoconferencia en vivo: Estados Unidos, Racismo en tiempos de Pandemia

Gobiernos de derecha en Suramérica no pueden controlar el coronavirus:

África: El “socialismo africano”

El olvidado precursor de los derechos civiles en América fue Juan Germán Roscio Nieves

África celebra su día mundial enfrentando unida al coronavirus y a una plaga de langostas

Primer buque iraní con combustible llega a aguas territoriales de Venezuela

¿Qué es la afrovenezolanidad? 74 voces lo dicen desde sus vivencias

María León, La Leona de Chávez, está de cumpleaños

Martes 19 de MAYO: La Geopolítica Mundial Post-pandemia. Video Conferencia. Hora ·3:00 PM

Pronunciamiento: Rechazo a la incursión naval contra la Soberanía Nacional de Venezuela

Venezuela: Centro de Saberes dio la bienvenida a la Cruz de Mayo

Heroínas anónimas: ¿Quién fue Teresa de Jesús Bolívar?

Velorio Virtual de Cruz de Mayo con el Grupo Herencia, link aquí
Video conferencia:Medicina alopática vs Medicina afro ancestral ¿Visiones incluyentes o excluyentes?

Hace 150 años nació Lenin, el creador de la Unión Soviética

El viral meme de los sepultureros viene de Ghana

Exigen a la dictadura de Bolivia, libertad de Irene Elena Flores Torrez

¡África no es laboratorio de nadie! MANIFIESTO

La OMS censura a los científicos franceses que quieren ensayar la vacuna en África: «Es colonialista y horrible»

África indignada con propuesta francesa de experimentar con su gente

Cuba: Ejemplo de humanismo, solidaridad y heroísmo frente al COVID-19

*¡Venezuela por siempre heroica y digna!* Manifiesto

Ciclo de Conferencias: “La nueva arquitectura financiera para la integración y el desarrollo de América latina y el Caribe”.

Centro de Saberes, en su IX Aniversario, lanzara maestrías sobre África y el Caribe

9 Años del Centro de Saberes Africanos, Americanos y Caribeños

Venezuela: 15 años de la Agenda África

Consul General de Angola visitó Centro de Saberes Africanos en Venezuela

Libia: Continua la crisis, paralizada industria petrolera

Guinea Bissau: Umaro Embaló, aprovecha división del PAIGC y es electo Presidente en 2a Vuelta

Haití: Cascos azules de la ONU abusaron sexualmente de 2.000 mujeres

Argelia: Muere Ahmed Gaid Salah, el General que salvó la Revolución

Reinaldo Bolívar: ALBA-TCP, gran esperanza para la integración de los pueblos

Abdelmadjid TEBBOUNE, presidente electo de Argelia

Luis Brito García: ¿Quiénes derrocaron a Evo?

Entrevista a Claudio Katz, ganador del Premio Libertador al Pensamiento Crítico 2018

La OEA de Almagro desestabiliza a Dominica

Putin: No hay poder en Bolivia. Me recuerda a Libia

Fortalecerán la divulgación del Pensamiento geopolítico de Hugo Chávez

Biografía de un cimarrón por Miguel Barnet

Centro de Saberes Africanos abrirá diplomado sobre religiones

Habla Inglés, Francés, Italiano, Chino Mandarín, Portugués. Aprende en el Centro de Saberes

África aplica vacuna, creada por sus científicos, contra el ébola

Libia: Invasión, resistencia y ofensiva

Conforman Secretaría Afrodescendiente del Foro de Sao Paulo

¿Que esperar del Foro Sao Paulo y el MNOAL en Venezuela?

Colombia, Bolívar y Rondón

Senegal y Argelia a la final de la Copa Africana de Naciones

Movimiento Afrovenezolano se manifiesta ante la aprehensión del asesino de Orlando Figueras

Sudán: Gobierno y oposición acuerdan compartir el poder por 3 años

¿De quién es el infame informe Bachelet? ¿Qué hacer?

Copa África: Benin sorprende a Marruecos y lo elimina

Así va la Copa África de Naciones, Egipto 2019

El sargazo: marea de algas fétidas invaden al Caribe

24 de junio: Países andinos celebran el Inti Raymi o “fiesta del Sol”

La esperanza de San Juan resonó en Caracas

Abortan golpe de Estado en Etiopía

Falleció Marta Harnecker, una de las más grandes figuras de la izquierda Nuestro Americana

Sudáfrica cierra campaña electoral con Ramaphosa como favorito

La Cruz de Mayo hizo vibrar a Caracas

Pueblo venezolano celebra con gran movilización el Día del Trabajador

Operación libertad, origen y fines
¿Quieres apoyar al Centro de Saberes en su labor?

Sudán: ¿golpe palaciego o intervención extranjera?

OPORTUNIDADES DE FORMACIÓN

Mali, un caso crítico de la inestabilidad en el Sahel

Argelia: Abdelkhader Bensalah, presidirá temporalmente la nación

Argelia ¿Revuelta espontánea o desestabilización premeditada y organizada?

Renuncia en su último mes de mandato Bouteflika, Presidente de Argelia.

Lavrov asegura que el apoyo de Moscú a Caracas es «inquebrantable»

Venezuela: Guaidó hace llamado a saquear propiedad privada

Presidente de Argelia anuncia postergación de elecciones y renuncia a ser candidato

Venezuela bajo ataque: 7 apuntes sobre el shock eléctrico

Muhammadu Buhari reelecto Presidente de Nigeria

EEUU: todo el manual contra Venezuela

Abiertas las Inscripciones para el Seminario: Historia y cultura de Guinea Ecuatorial y África Central

El Centro de Saberes Africanos, Americanos y Caribeños ante las amenazas contra Venezuela

El GLima, la OEA y su arremetida contra el Derecho Internacional

Estas son las elecciones africanas claves para ver en 2019.

AMLO, un presidente que se arrodilló ante el pueblo

Túnez aprueba la ley de herencia igualitaria

¿Por qué es necesario que el pueblo venezolano hable un idioma originario?

La izquierda de Brasil y su peor campaña electoral

Las mujeres volvieron a tomar las calles de Brasil para rechazar a Jair Bolsonaro: “Juntas somos más fuertes”

Embajada de Ecuador planifica su mes afro en Venezuela

Conozca las amenazas a la Integración en Nuestra América

El Multilateralismo agoniza

Viernes 28 de Septiembre «Pantera Negra», en el Cine-Foro del Centro de Saberes Africanos, Americanos y Caribeños

Hacia los 50 años de la Independencia de Guinea Ecuatorial

19 y 20 de septiembre: Debatirán sobre las amenazas político militares a la integración de nuestra américa

Viernes 17 de agosto Documental «Panteras Negras.Todo el Poder para el Pueblo» en el Cine-Foro del Centro de Saberes Africanos, Americanos y Caribeños

Reinaldo Bolívar: El método del magnicidio una amenaza recurrente

El verdadero tamaño de África

Vicerrector del Instituto Superior de Relaciones Internacionales de Mozambique en el Centro de Saberes Africanos

Viernes 29 de junio Película «El Gran Debate», en el Cine-Foro del Centro de Saberes Africanos, Americanos y Caribeños

Elecciones en Venezuela

Reinaldo Bolívar: Los gobiernos deben dejar que se desarrolle la Diplomacia de los Pueblos

Nigeria: Lider de Boko Haram huye disfrazado de mujer

¡El Carnaval también viene de África!

Recursos naturales y soberania factor de desarrollo de los pueblos

Un futbolista profesional será presidente de Liberia

Amorosa Nochebuena

2017 el año clave para la humanidad

Partido de Gobierno de Sudáfrica elige a sucesor de Zuma

Nuestro Mensaje de Navidad y Año Nuevo

DECLARACIÓN DE LOS ARTISTAS Y CULTORES: V FESTIVAL CULTURAL CON LOS PUEBLOS DE ÁFRICA

Programación del Festival

Guaicaipuro Cuatemoc cobra la deuda a Europa

XII Semana Mundial de África en Venezuela inicia este martes

Resumen de Noticias de ÁFRICA

Manifestantes estadounidenses pueden enfrentar 75 años de prisión por protestar contra Trump

Solicitan 1, 4 millones de dólares para refugiados sursudaneses

Legisladores angoleños preparan votación de cambios a ley tributaria

Presidente de Guinea Bissau se solidariza con la Revolución Bolivariana

Panameños exigen neutralidad del Canal ante posibles conflictos

Muchos problemas del mundo no existirían si EEUU no invirtiera en la guerra e intervencionismo, dice Morales

OIM alerta: refugiados son vendidos como esclavos en Libia

Revelan nuevos datos sobre abusos sexuales de los cascos azules en Haití

Lenín Moreno es el nuevo presidente de Ecuador

Reservas de divisas de Egipto alcanzan un máximo quinquenal

Venezuela y Sudán celebran II Reunión del Mecanismo de Consultas Políticas

Protestas para forzar dimisión del presidente de Guinea Bissau

Mecanismo regional acuerda fondo para reformar Somalia

Sahelistán del Nilo al Atlántico

Ratifica Egipto apoyo a causa palestina

Lluvias más intensas amenazan con agravar inundaciones en Perú esta semana

Terroristas intentan romper cerco en zona cercana a Damasco

Venezuela repudia campaña mundial contra el Papa Francisco

Intelectual senegalesa valoró iniciativa de difusión de conocimientos africanos en Venezuela

Viceministro Reinaldo Bolívar instaló I Reunión de Mecanismo de Consultas Políticas Venezuela-Guinea Ecuatorial

Rodríguez: Venezuela avanza en la consolidación del relacionamiento con África

ONU: La igualdad de género es una deuda aún por saldar

Somalíes expresan indignación por base militar emiratí en su país

El Ascenso al Panteón Nacional de las Heroínas Apacuana, Hipólita Bolívar y Matea Bolívar

Viceministro Reinaldo Bolívar: Mantener la integración regional es la mejor forma de enfrentar las arremetidas del imperialismo

Libertad religiosa a debate parlamentario en Angola

Mueren 20 personas por ataque con coche bomba en Somalia

Presentan en Malí edición en francés del libro “Venezuela y África. Las nuevas relaciones”

RDCongo busca explotar potencialidades turísticas

Panameños se oponen a nuevo puerto en Canal de Panamá

Países productores reforzarán coordinación en función del acuerdo de recorte petrolero

Inicia visita a Egipto presidente de Líbano

Portugal expresa interés en diversificación económica angoleña

Viceministro Reinaldo Bolívar: Presencia de Apacuana, Hipólita y Matea en el Panteón Nacional da muestra de la conformación de nuestra identidad

Viceministro Bolívar se reunió con candidato de la Unión Africana al FIDA

Unos 65 mil uniformados ocuparán zonas dejadas por salida FARC-EP

Tunecinos rechazan regreso de sus compatriotas terroristas al país

Venezuela presente en XXVIII cumbre de la Unión Africana

Oposición rehúye del diálogo por temor a perder apoyo de radicales

Muerte de dos peloteros dominicanos deja al béisbol mundial de luto

ONU alerta sobre violaciones de los DD.HH en Sudán del Sur

Venezuela presentará nueva propuesta a países petroleros para estabilizar mercado

Tribunal de Egipto rechaza apelación sobre islas del Mar Rojo

Militares se amotinan en Costa de Marfil

Misión gubernamental viaja a provincia angoleña por brote de cólera

Venezuela se afianza como país con amplia diversidad cultural

Venezuela: Posible acuerdo Colombia-OTAN viola paz de Suramérica

Recupera Egipto cientos de artefactos antiguos desde Jordania

Mensaje de navidad y año nuevo del Centro de Saberes Africanos, Americanos y Caribeños

Organismo afro-occidental condena ataque a base burkinabesa

Reconquista de Sirte, importante paso para liberación de Libia

Libia, un puzzle sangriento

Viceministro Reinaldo Bolívar apadrinó a graduandos de IV Cohorte de Medicina Integral Comunitaria de la ELAM

Presupuesto de 2017 va a parlamento angoleño para votación final

Venezuela optimiza cono monetario con nuevos billetes y monedas

Partido Comunista de Uruguay: Acción contra Venezuela en Mercosur es un grave error político

Zuma: Mandela levantó una Sudáfrica sobre las cenizas del apartheid

Venezuela alberga XXI Cumbre Social del Mercosur

Venezuela y Argelia definieron acciones conjuntas en defensa del precio petrolero

Las ideas de Fidel perdurarán en el tiempo, Sam Nujoma

Wayde van Niekerk, estrella del deporte del año en Sudáfrica

Resultados preliminares de referendo boliviano sobre autonomía

Se incrementan a 21 los muertos en reyerta tribal en Libia

Mugabe abre posibilidad de retiro antes de elecciones del 2018

Mueren 10 musulmanes nigerianos en enfrentamientos con la policía

Más de 17 millones de sudafricanos reciben ayuda del gobierno

Siria y Argelia por elevar la cooperación en diversas áreas

Mozambique necesita coraje para enfrentar crisis, afirma expresidente

Los Cumbes

Mes de la Herencia Hispana, imperfecto pero necesario

Sudafricanos deben sentir orgullo de su rica herencia cultural

Margarita lista para acoger Cumbre MNOAL

Ocho muertos y 87 heridos por explosión en vertedero de Benín

Paradojas brasileñas

Visitas dirigidas a la sede académica del «Centro de Saberes Africanos, Americanos y Caribeños»
Programación y Anuarios de Actividades
Misión y Visión
Centro de Saberes Africanos, Americanos y Caribeños

Un programa de terapia con caballos en Namibia lleva alegría a niños con discapacidades de aprendizaje

Un incendio en Ciudad del Cabo obliga a la evacuación de casi 200 hogares

Uganda declara el fin del último brote de ébola

Colaboración transfronteriza favoreció programas de salud en África

Presidente Saïed visita stand de Venezuela en Túnez

Un sismo de magnitud 6.4 sacudió las costa de Ecuador este viernes. Hasta el momento no se reportar victimas informó la Secretaría de Gestión de Riesgos

Líderes mundiales se congregan en Roma para honrar la memoria del Papa Francisco

Intromisión: El FMI llamó explícitamente a votar por los candidatos de Milei

Delegaciones de Irán y EEUU tendrán conversaciones indirectas en Omán

China rechaza presiones de EEUU sobre América Latina y el Caribe

Congreso Internacional de Emprendimiento comienza en Venezuela




